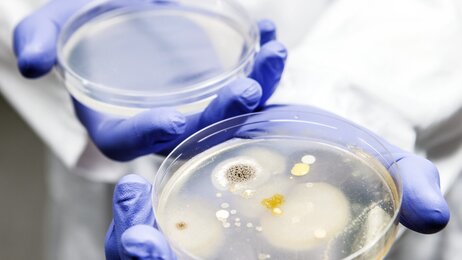
Bildet viser petridisker med bakterievekster.

Sigurd Høye
Allmennlege, førsteamanuensis og lederFagerborglegene og Antibiotikasenteret for primærmedisin, Avdeling for allmennmedisin, Universitetet i Oslo Send e-post
Innlegg av Sigurd Høye som allmennlege, førsteamanuensis og leder:
Antibiotikasmarte sykepleierstudenter? Sykepleierstudenters kunnskap og egenvurdert kompetanse om antibiotikabruk og -resistens
De vurderer selv at de har lite kunnskap og lav kompetanse om disse temaene.
– Knus mytene om antibiotika
– Det finnes mange myter om antibiotika. De fleste av dem kan med fordel knuses, skriver lederen for Antibiotikasenteret for primærmedisin.